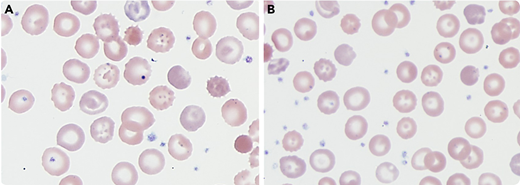
A 4-year-old boy with a history of developmental delay, hypersplenism, thrombocytopenia, transfusion-dependent anemia, and recently identified phosphoglycerate kinase-1 (PGK1) gene mutation (NM_000291.3; variant c.472G>C; p.Gly158Arg) with decreased PGK activity (<17% of normal mean) presented for follow-up 2 months after splenectomy. The patient was receiving blood transfusions every 2 to 3 weeks before splenectomy. After splenectomy, the complete blood count (CBC) numbers were not as critical as before, and no regular blood transfusions were required. His bloodwork showed hemoglobin of 9.6 g/dL, hematocrit 29.2%, red blood cell (RBC) count 2.93 × 106/μL, mean corpuscular volume 99.7 fL, reticulocytes >17.97%, and absolute reticulocyte count 0.5117 × 106/μL.

A 4-year-old boy with a history of developmental delay, hypersplenism, thrombocytopenia, transfusion-dependent anemia, and recently identified phosphoglycerate kinase-1 (PGK1) gene mutation (NM_000291.3; variant c.472G>C; p.Gly158Arg) with decreased PGK activity (<17% of normal mean) presented for follow-up 2 months after splenectomy. The patient was receiving blood transfusions every 2 to 3 weeks before splenectomy. After splenectomy, the complete blood count (CBC) numbers were not as critical as before, and no regular blood transfusions were required. His bloodwork showed hemoglobin of 9.6 g/dL, hematocrit 29.2%, red blood cell (RBC) count 2.93 × 106/μL, mean corpuscular volume 99.7 fL, reticulocytes >17.97%, and absolute reticulocyte count 0.5117 × 106/μL.
A peripheral blood smear was performed, and it revealed some unusual cytomorphologic features that could be characteristic for the patient’s known PGK1 mutation and have not been well described: pointy and round RBC membrane deformations and invaginations (panels A and B; original magnification ×1000; Wright-Giemsa stain). The previously defined findings (namely echinocytes, polychromasia, and nucleated RBCs) were seen on this patient’s peripheral blood smear as well. PGK1 gene mutations are known to reduce the activity of PGK, which dysregulates normal energy production and could cause cell damage. The reason why this abnormality preferentially affects RBCs and brain cells is ambiguous. The patient’s CBC numbers are closely monitored, and blood transfusion is recommended if clinically relevant.
A 4-year-old boy with a history of developmental delay, hypersplenism, thrombocytopenia, transfusion-dependent anemia, and recently identified phosphoglycerate kinase-1 (PGK1) gene mutation (NM_000291.3; variant c.472G>C; p.Gly158Arg) with decreased PGK activity (<17% of normal mean) presented for follow-up 2 months after splenectomy. The patient was receiving blood transfusions every 2 to 3 weeks before splenectomy. After splenectomy, the complete blood count (CBC) numbers were not as critical as before, and no regular blood transfusions were required. His bloodwork showed hemoglobin of 9.6 g/dL, hematocrit 29.2%, red blood cell (RBC) count 2.93 × 106/μL, mean corpuscular volume 99.7 fL, reticulocytes >17.97%, and absolute reticulocyte count 0.5117 × 106/μL.
A peripheral blood smear was performed, and it revealed some unusual cytomorphologic features that could be characteristic for the patient’s known PGK1 mutation and have not been well described: pointy and round RBC membrane deformations and invaginations (panels A and B; original magnification ×1000; Wright-Giemsa stain). The previously defined findings (namely echinocytes, polychromasia, and nucleated RBCs) were seen on this patient’s peripheral blood smear as well. PGK1 gene mutations are known to reduce the activity of PGK, which dysregulates normal energy production and could cause cell damage. The reason why this abnormality preferentially affects RBCs and brain cells is ambiguous. The patient’s CBC numbers are closely monitored, and blood transfusion is recommended if clinically relevant.
For additional images, visit the ASH Image Bank, a reference and teaching tool that is continually updated with new atlas and case study images. For more information, visit http://imagebank.hematology.org.
This feature is available to Subscribers Only
Sign In or Create an Account Close Modal